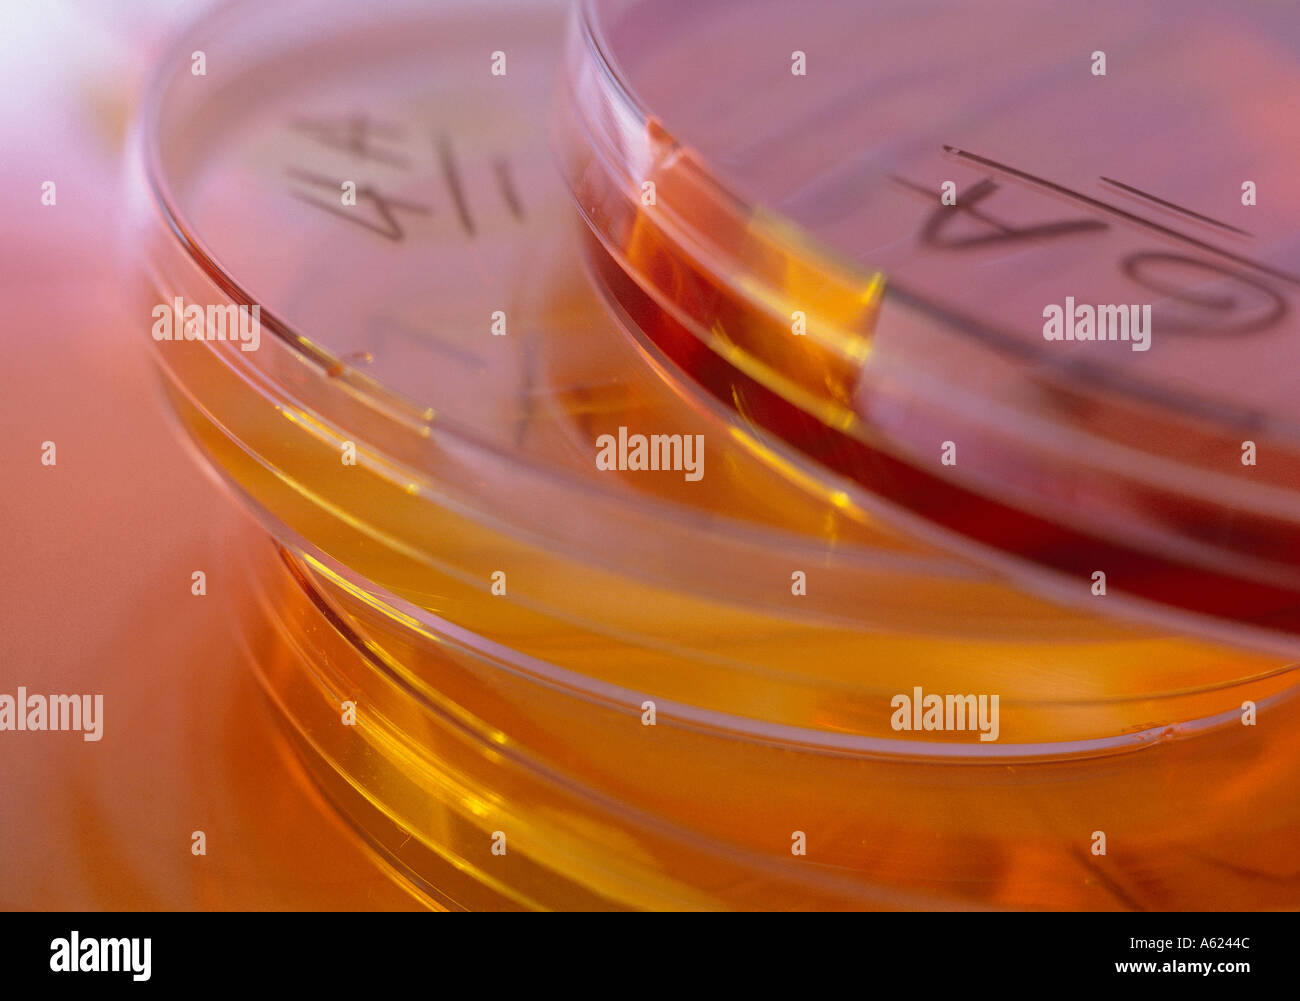
Medicina di Laboratorio per la salute Foto Stock

Medicina di Laboratorio per la salute
RMID:ID dell’immagine:A6244C
Detagli dell'immagine
Collaboratore:
Eye UbiquitousID dell’immagine:
A6244CDimensioni dei file:
37,4 MB (1,7 MB Download compresso)Liberatorie:
Modello - no | Proprietà - noMi occorre una liberatoria?Dimensioni:
4318 x 3028 px | 36,6 x 25,6 cm | 14,4 x 10,1 inches | 300dpiUbicazione:
MEDICAL Health LaboratoryFotografo:
Eye UbiquitousAltre informazioni: